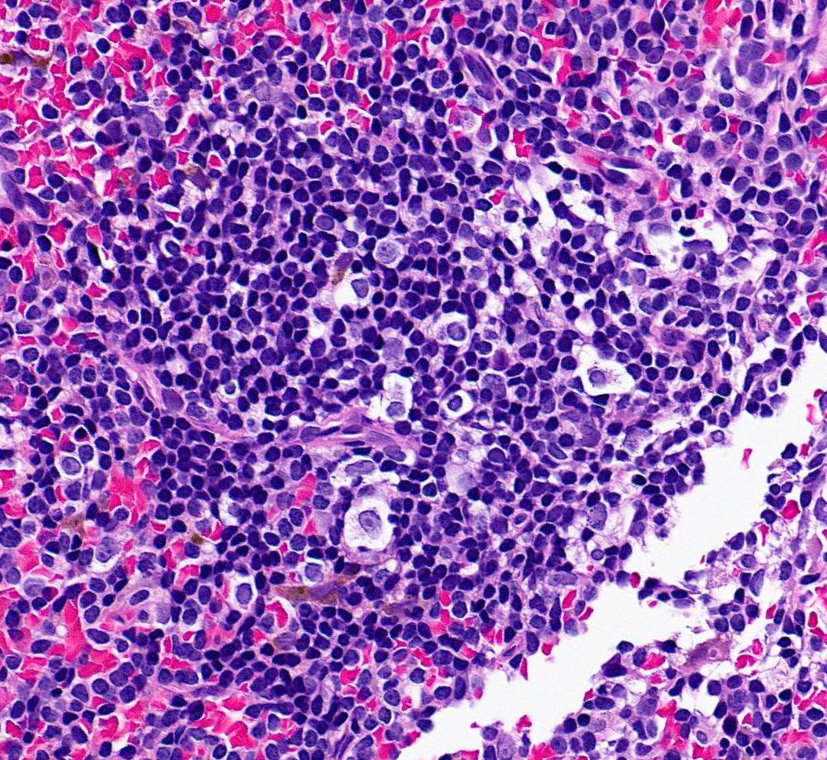
SibaElHussein's tweet image. Autoimmune myelofibrosis:

🩸Defined as marrow fibrosis &amp;amp; lymphocytic aggregates in the context of an established autoimmune disorder (secondary) or autoantibodies without a defined disorder (primary)

#hemepath #pathtwitter #leusm #bmtsm #BMT

Botond Timar
@BotondTimar
MD, PhD Hematopathologist, Molecular Pathologist #Traveller, #Coffe and #Tea fan and others ↪Tweets/RTs are mine and not medical advice
You might like
tour de force … lots of cool data to dig into #hemapath @CellCellPress Congrats to the authors sciencedirect.com/science/articl…

Out today @AjHematology More reason I ♥️ NPM1 IHC…. When cytoplasmic & you don’t find a mutation… U should suspect NPM1 rearrangement We argue NPM1-r myeloid neoplasms should be considered AML irrespective of blast % Congrats to Dr. Sameeta #hemepath onlinelibrary.wiley.com/doi/epdf/10.10…

Just had a chance to read this round-table discussion on trials for myeloma precursors. Non pay-walled link: drive.google.com/file/d/1eAlv5_… With no disrespect to the stellar authors, this was a painful read that lacked context/nuance , and I highlight in this thread. #mmsm 1/

Illustration of thyroid MALT lymphoma with “MALT ball”-type lymphoepithelial lesions, consisting of lymphoma cells surrounded by a ring of thyroid follicular epithelial cells #hemepath #lymsm #Surgpath #PathX #PathTwitter #MedEd #SoMe #CytoPath #Headandneckpath Picture from…


Our DLBCL chapter with @FVega957 ➡️shorturl.at/fmnGY🩸🔬 #hemepath #lymsm #molpath #pathtwitter #medtwitter #pathX #MedX #SoMe #MedEd #bmtSM

Our book is online 🎉 The opportunity to edit this book with my friend, the most wonderful @evemariecrane was the best part of this journey. 1/ link.springer.com/book/10.1007/9… #hemepth #lymsm


🩸Indolent T lymphoblastic proliferation (IT-LBP) is an extra-thymic non-clonal expansion of T-lymphoblasts 🩸It occurrs alone or in association with other disorders, including Castleman disease (as illustrated in below Figures 1-3) and others (myasthenia gravis, hepatocellular…




Kaposi sarcoma herpesvirus/human herpesvirus 8 (KSHV/HHV8)-associated multicentric Castleman disease (KSHV/HHV8-MCD) is a lymphoproliferative disorder with: 🩸 idiopathic multicentric Castleman disease-like morphology (Figure 1 below) 🩸 KSHV/HHV8-infected plasmablasts (Figure 2…




Reactive plasmacytoid dendritic cells (PDCs) vs Blastic Plasmacytoid Dendritic Cell Neoplasm (BPDCN) by flow cytometry analysis➡️ Reactive PDCs: brightly positive for CD38 and CD123, positive for CD303 and HLA-DR,with subset CD2 positivity, and CD7 negativity. #hemepath


When I read an #ASH23 abstract that asks whether PFS or MRD is a surrogate endpoint in FL (L) or CLL (R), I know instantly the person on the left did it right and the person on the right messed up Want to learn how? & diff btw Prognostic, predictive & surrogate #Tweetorial

👇#OriginalResearch #OpenAccess🔓 "Faster than light (microscopy): superiority of digital pathology over microscopy for assessment of immunohistochemistry" by Clarke et al. jcp.bmj.com/content/early/… #digitalpathology #IHCpath #pathinformatics




Great example of IgG4 sclerosing lymphadenopathy 🔸Follicular hyperplasia 🔸Paracortical plasma cells 🔸Fibrosis + storiform pattern 🔸May be isolated, part of systemic disease or 2nd to other pathologies Nice review by @Vik_deshpandeMD : pubmed.ncbi.nlm.nih.gov/32889888/ #hemepath




New in Pathology & #OncologyResearch! @semmelweishu researchers, including @BotondTimar, explore the correlation between growth-related biomarker expression in bone marrow stromal cells and #myelofibrosis. 👀Read the full text to see what they found. fro.ntiers.in/POR-1610217

Autoimmune myelofibrosis: 🩸Defined as marrow fibrosis & lymphocytic aggregates in the context of an established autoimmune disorder (secondary) or autoantibodies without a defined disorder (primary) #hemepath #pathtwitter #leusm #bmtsm #BMT

10 myths about small cell carcinoma of lung: 1. TTF-1 positivity in small cell carcinoma confirms lung primary (FALSE! 20% of small cell lung carcinomas are TTF-1 negative)2. Large cells exclude... kikoxp.com/posts/20731

I love cases that make me think.. Never a dull day at #hemepathMDA Tune in: a #hemepath #MDSSM case for your learning pleasure.. Enjoy! This is the bone marrow of an elderly woman (>65 yr) with marked pancytopenia and progressive transfusion dependency. 🧵 1/

✒️Here is my second "big list" of cases: ⚕️Gastrointestinal pathology ~70 cases (I think I got them all!)⚕️ kikoxp.com/posts/18611 #GIpath #HPBpath #PathTwitter #pathresidents #Medtwitter
Back with another episode of #WHOHEME this time covering what’s new (or old but gold) in Follicular Lymphoma #hemepath #LymSM … diagnostic pearls 🔬 @WHO 5th ed recognizes 5 flavors of FL… tune in & remember ISFBN, pediatric, duodenal and primary cutaneous are very indolent 1/

#hemepath This one is for @IHC_guy. What's the diagnosis? LN, Older male. Maybe more than one thing going on?

Novel Approaches in Molecular Characterization of Classical Hodgkin Lymphoma mdpi.com/1705900 #lymsm #mdpicancers via @Cancers_MDPI

United States Trends
- 1. Staged N/A
- 2. #CHANGEVERSE2026 N/A
- 3. Good Wednesday N/A
- 4. #WonderMan N/A
- 5. #EverydayStrongSkinWithJimmy N/A
- 6. JIMMY DERMBUDDY NUFORMULA N/A
- 7. Ilhan Omar N/A
- 8. Musetti N/A
- 9. Djokovic N/A
- 10. Ben Shelton N/A
- 11. Pond N/A
- 12. Dort N/A
- 13. Sinner N/A
- 14. Kendrick N/A
- 15. Jussie Smollett N/A
- 16. J Cole N/A
- 17. Simon Williams N/A
- 18. Miguel Cabrera N/A
- 19. maisie N/A
- 20. Purdue N/A
Something went wrong.
Something went wrong.












































































































